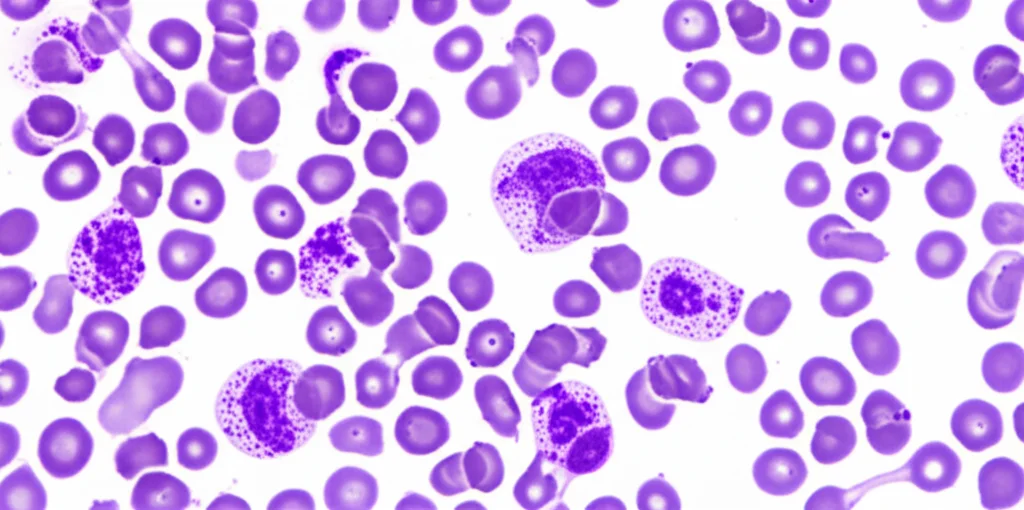
Primo piano di cellule del midollo osseo al microscopio, con evidenziazione di cellule eritroidi displastiche e blasti. Illuminazione controllata per dettagli morfologici, obiettivo macro 100mm, stile documentaristico scientifico.

MDS e Leucemia Eritroide con TP53 Mutato: Ruxolitinib e Trapianto, l’Alba di una Nuova Speranza?
Amici, oggi vi porto nel cuore pulsante della ricerca ematologica, dove ogni piccolo passo avanti può significare un mondo per chi lotta contro malattie complesse. Parliamo di quelle forme particolarmente ostiche di sindromi mielodisplastiche (MDS) e di leucemia eritroide acuta (AEL), soprattutto quando presentano le temute mutazioni del gene TP53 e un cariotipo complesso. Per chi non lo sapesse, il TP53 è una specie di “guardiano del genoma”, e quando non funziona a dovere, le cellule possono impazzire e diventare cancerose. Queste condizioni, purtroppo, hanno una prognosi spesso infausta e rispondono poco alle terapie convenzionali.
Una Bestia Nera Chiamata MDS/AEL con TP53 Mutato
Quando parliamo di MDS con predominanza eritroide o di AEL, ci riferiamo a malattie caratterizzate da una proliferazione anomala dei precursori dei globuli rossi nel midollo osseo. La situazione si complica ulteriormente con le mutazioni “multi-hit” di TP53, che rendono queste patologie particolarmente aggressive e refrattarie ai trattamenti. Immaginatevi un nemico che non solo è forte, ma conosce anche tutti i vostri trucchi per sconfiggerlo. La sopravvivenza media, in questi casi, si misura in pochi mesi. Il trapianto allogenico di cellule staminali (allo-SCT) rappresenta, ad oggi, l’unica opzione potenzialmente curativa, ma anche qui le ricadute sono frequenti. C’è un disperato bisogno di nuove strategie.
Recenti studi hanno iniziato a far luce sulle caratteristiche genomiche di queste malattie, scoprendo che circa il 39% dei pazienti con AEL presenta mutazioni di TP53. Interessante, vero? Ma c’è di più: in queste forme TP53-mutate, si osserva spesso un’iperattivazione del cosiddetto pathway di JAK-STAT, una via di segnalazione cellulare cruciale. Questo ha acceso una lampadina nei ricercatori: e se provassimo a inibire questa via? Modelli preclinici, utilizzando un farmaco chiamato ruxolitinib (un inibitore di JAK2), hanno mostrato risultati promettenti.
Un Caso Clinico Che Accende la Speranza
E qui, amici, vi racconto una storia che, pur essendo un singolo caso, apre scenari davvero incoraggianti. Immaginate un uomo di 50 anni, precedentemente sano, che si presenta in ospedale con febbre e mal di gola. Gli esami rivelano anemia e altre anomalie. Dopo approfondimenti, la diagnosi è impietosa: MDS con mutazioni multi-hit di TP53 e un cariotipo complesso, una condizione sull’orlo di trasformarsi in AEL vera e propria, data l’altissima percentuale di precursori eritroidi (>80%).
Si tenta subito un approccio con venetoclax e azacitidina, scelto per la nota chemioresistenza di queste forme. Niente da fare, la malattia progredisce. Si passa a daunorubicina e citarabina, un altro classico. Ancora un fallimento. Un ultimo tentativo con alte dosi di citarabina per ridurre la massa tumorale, ma il midollo resta ipercellulare e i blasti aumentano. La situazione è critica.
A questo punto, si decide per il trapianto allogenico di cellule staminali da donatore compatibile, come terapia di salvataggio. Il trapianto va relativamente bene, a parte una lieve malattia da trapianto contro l’ospite (GvHD) cutanea, gestita con steroidi topici. Ma l’esame del midollo a un mese dal trapianto mostra ancora la presenza di cellule leucemiche residue e un chimerismo del ricevente del 5%. Le cellule malate, con TP53 mutato, sono ancora lì, raggruppate in alcune aree del midollo. Non è la remissione completa che si sperava.
Qui arriva la svolta, o almeno, il tentativo di darla. Per potenziare l’effetto graft-versus-leukemia (GVL) – ovvero, la capacità delle cellule del donatore di attaccare le cellule leucemiche residue – si decide di ridurre rapidamente il tacrolimus, un farmaco immunosoppressore. Contemporaneamente, si introduce il ruxolitinib, con l’obiettivo primario di colpire direttamente l’attività leucemica, basandosi sui dati preclinici che suggerivano un ruolo critico della via EPOR/JAK-STAT in queste patologie.
Inizialmente, il ruxolitinib viene dato a 20 mg/giorno, poi aumentato a 40 mg, ma ridotto nuovamente a 20 mg a causa di citopenia. Due mesi dopo la sospensione del tacrolimus, si sviluppa una GvHD cronica orale ed epatica, che richiede la reintroduzione del tacrolimus. Ma la notizia bomba è un’altra: l’esame del midollo osseo non rileva più cellule leucemiche! Né con la citometria a flusso, né con la colorazione per p53. È una remissione ematologica completa.
Analizzando l’evoluzione clonale tramite Next-Generation Sequencing (NGS), si vede chiaramente come il clone con TP53 mutato, dominante all’inizio e persistente dopo le varie chemio, sia stato quasi completamente eradicato dalla combinazione di trapianto, rapida riduzione del tacrolimus e ruxolitinib. A otto mesi dal trapianto, il paziente è ancora in remissione completa.
Perché Questa Combinazione Potrebbe Funzionare?
Ci sono almeno due spiegazioni plausibili per questo successo.
- Azione diretta del Ruxolitinib: Le leucemie TP53-mutate sono spesso associate a un’iperattivazione della via EPOR/JAK/STAT. L’NGS del paziente aveva rivelato un’amplificazione sul cromosoma 6p, che include il locus PIM1. PIM1 è un effettore a valle della via JAK/STAT. Il ruxolitinib, inibendo JAK2, potrebbe aver contribuito direttamente a sopprimere il tumore bloccando questa via iperattiva.
- Potenziamento del GVL e controllo della GvHD: Il ruxolitinib potrebbe aver mantenuto o addirittura potenziato l’effetto GVL, mentre contemporaneamente sopprimeva la GvHD che poteva derivare dalla rapida riduzione del tacrolimus. È noto che il ruxolitinib può migliorare gli esiti della GvHD steroido-refrattaria mantenendo l’effetto GVL, modulando la funzione delle cellule immunitarie senza compromettere la loro capacità di colpire le cellule leucemiche.
In pratica, l’uso concomitante di ruxolitinib durante la riduzione del tacrolimus potrebbe aver prevenuto una GvHD severa, pur consentendo all’effetto GVL di manifestarsi con forza. Gli effetti sinergici di questi meccanismi potrebbero essere stati cruciali per superare la natura aggressiva di questa forma di MDS/AEL.

Cosa Ci Dice Questo Caso?
Amici, questo è il primo caso riportato che dimostra l’efficacia della terapia combinata con trapianto allogenico e ruxolitinib in una MDS/AEL multi-hit TP53-mutata con cariotipo complesso. È una singola rondine che non fa primavera, certo, ma accende una luce di speranza enorme. Questo approccio offre un’opzione promettente per affrontare la chemioresistenza e gli alti tassi di ricaduta in questi pazienti sfortunati.
Ovviamente, come sempre nella scienza, sono necessari ulteriori studi per valutare l’efficacia e la sicurezza di questa strategia in un contesto clinico più ampio. Ma il primo passo, quello che ti fa dire “Forse ci siamo”, è stato fatto. E noi continueremo a seguire con il fiato sospeso ogni sviluppo.
Fonte: Springer







